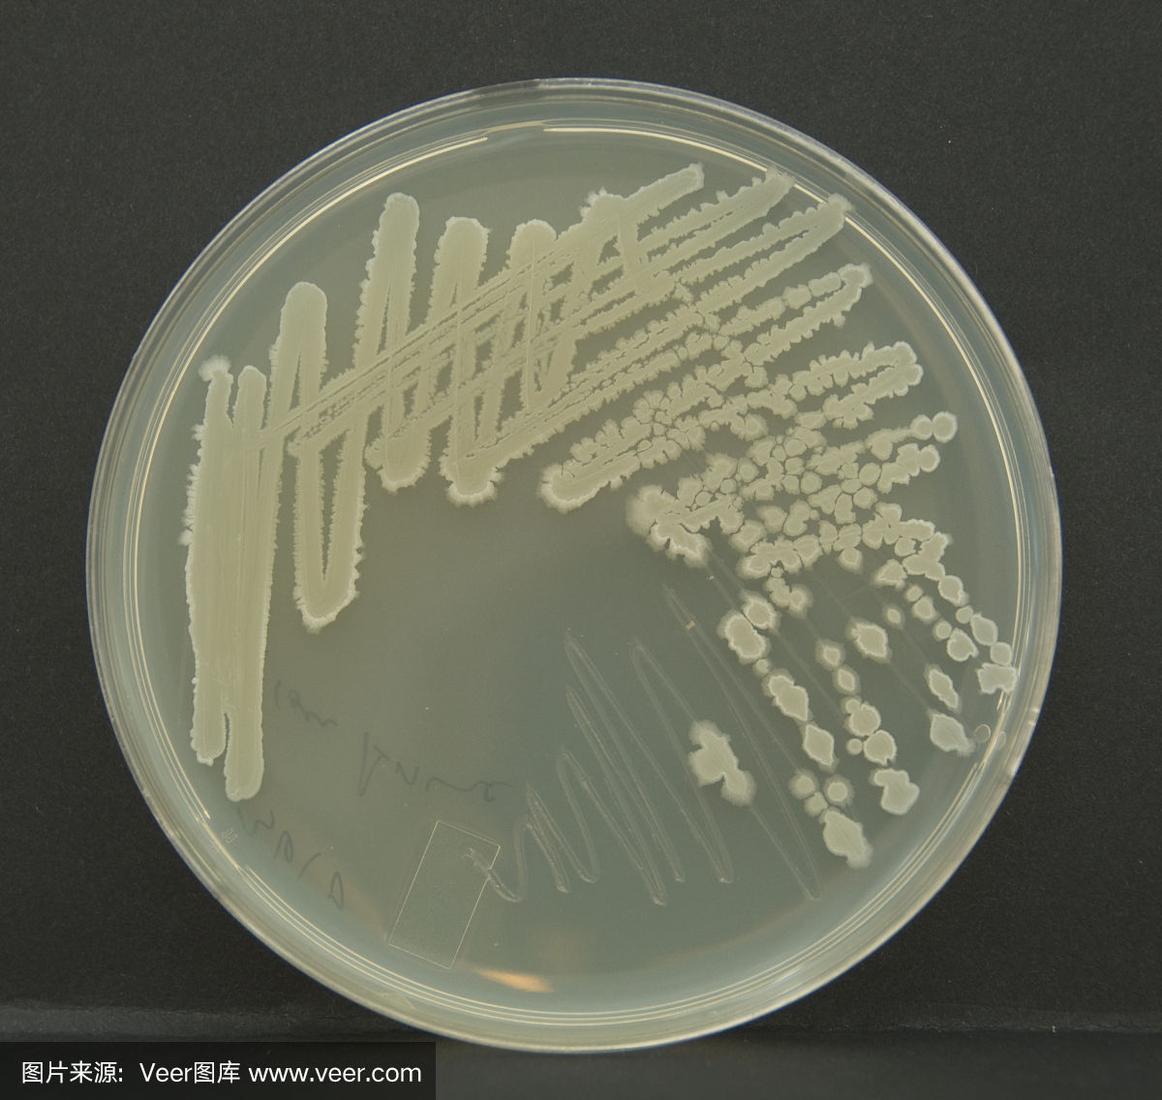
什么是细菌,病毒,真菌?它们都引起哪些感染性疾病?

细菌长什么样子图片

海边巨型细菌曝光!比人眼睫毛还长,你绝对不能错过!
图片尺寸660x498
罕见细菌在日本大爆发,感染速度惊人,恐成新一轮疫情风暴!
图片尺寸1104x792
细菌图片 素材 细菌
图片尺寸960x1280
微生物细菌形态
图片尺寸4032x3024
电子显微镜下针尖上的细菌
图片尺寸1097x1280
罕见细菌在日本大爆发,感染速度惊人,恐成新一轮疫情风暴!
图片尺寸1108x820
保卫家庭健康,让家里洗手台干净如初
图片尺寸2048x1536
洗澡搓下来的黑泥到底是什么黑泥在1000倍显微镜下是什么样子
图片尺寸1280x934
求细菌的图片!
图片尺寸450x549
婴幼儿配方食品中常见微生物污染有哪些?
图片尺寸640x640
海边惊现超长细菌,比人的眼睫毛还长,引发探索欲望
图片尺寸980x603
支原体肺炎是个啥#支原体是一种常见的细菌感染,可以引起多种疾病,如
图片尺寸1920x1280
细菌的显微镜和放大图片
图片尺寸1200x1005
细菌的形状多样化,包括了杆菌,球菌和螺旋菌等.它们不仅
图片尺寸640x323
在显微镜下的细菌
图片尺寸620x620
什么是细菌,病毒,真菌?它们都引起哪些感染性疾病?
图片尺寸1162x1100
25张通过显微镜拍到的罕见照片|细胞|细菌|血管|肉眼_网易订阅
图片尺寸606x600
"致命细菌"正向北迁徙,感染后死亡率近20%
图片尺寸1080x608
细菌_人体_种植
图片尺寸2048x1536
收藏|56张图片带您认识细菌长啥样?
图片尺寸576x447